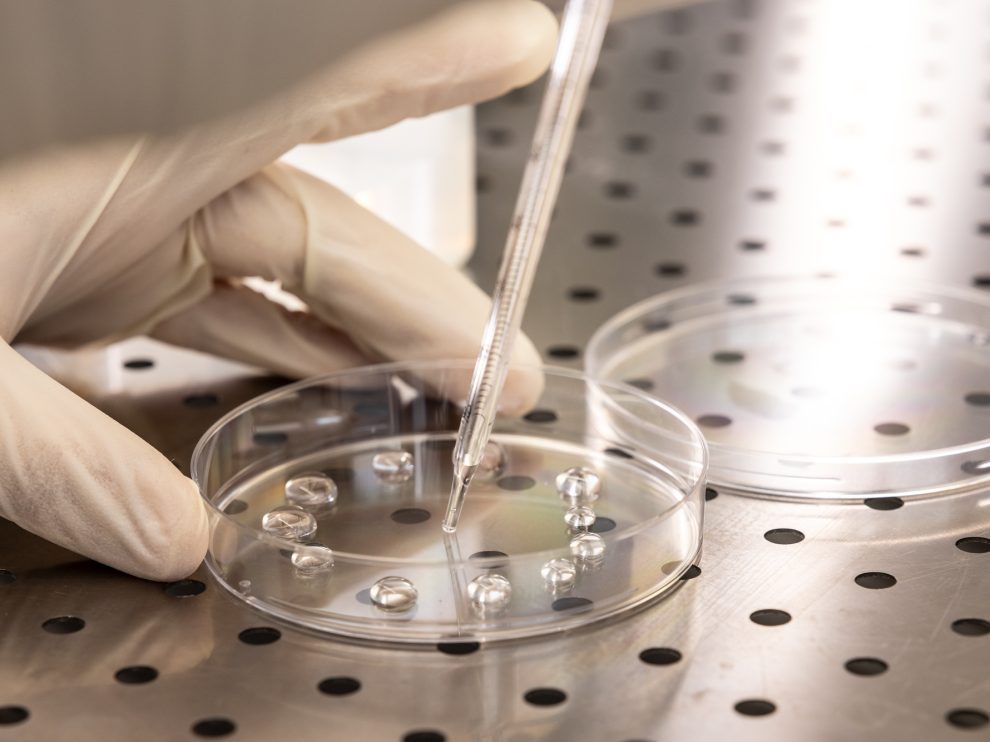
laboratorio analisi acque

Fiora per la Giornata Mondiale dell’Acqua
22 marzo
Il tema per il 2026 è Water and gender, in altre parole il legame invisibile ma determinante tra l’acqua e la parità di genere: “dove scorre l’acqua cresce l’uguaglianza”, citando il messaggio promosso dalla campagna comunicativa delle Nazioni Unite.
News ed eventi
Che cliente sei?
Scegli il percorso più adatto alle tue esigenze per scoprire i servizi dedicati ai clienti che hanno bisogno di gestire l’utenza idrica della propria Casa, della propria Azienda o i servizi dedicati agli Amministratori di Condominio.
Che cliente sei?
Scegli il percorso più adatto alle tue esigenze per scoprire i servizi dedicati ai clienti che hanno bisogno di gestire l’utenza idrica della propria Casa, della propria Azienda o i servizi dedicati agli Amministratori di Condominio.



I nostri asset
Da 22 anni la più vasta Conferenza Territoriale della Regione Toscana
Domande frequenti
Più dell’80% dei clienti di AdF possiede un misuratore dotato di telelettura, pertanto non è più necessario inviare la lettura periodica. Grazie al sistema di telelettura e all’elevata precisione metrologica di cui sono dotati questi nuovi contatori intelligenti, la lettura sarà automatica.
Verifica il modello del tuo misuratore
Qualora il tuo misuratore non rientri tra quelli in telelettura, troverai l’indicazione del periodo in cui inviare l’autolettura nel primo foglio della bolletta nella sezione di riepilogo dei consumi.
Effettua una prima verifica in autonomia controllando che, a rubinetti chiusi, il contatore non rilevi passaggio di acqua. Qualora lo rilevasse, rivolgiti ad un idraulico di fiducia per la verifica e riparazione del guasto.
In caso di accertata perdita occulta dovuta ad un guasto della tubazione, a valle del contatore, non affiorante e non rintracciabile con le operazioni di normale diligenza, puoi presentare domanda di depenalizzazione alla sezione Perdita occulta.
Se l’anomalia non dovesse dipendere da una perdita occulta o altro guasto a carico dell’impianto idraulico, puoi richiedere la verifica del funzionamento del contatore: riceverai ulteriori informazioni su come inoltrare la richiesta contattando i nostri numeri di Attenzione al cliente (800 887755 da telefono fisso oppure 0564 448844 da telefono cellulare e dall’estero).
RICORDA
Nel caso in cui il contatore risultasse funzionante, i costi della verifica saranno a tuo carico.
Per info e costi dell’intervento accedi a Costi prestazioni.
Possono essere rateizzate le fatture che rientrano nei requisiti imposti dalla Delibera ARERA 655/2015. L’importo della fattura da rateizzare deve superare dell’80% il valore dell’addebito medio riferito alle bollette emesse nel corso degli ultimi 12 mesi. La richiesta può essere inoltrata entro 10 giorni dalla scadenza della bolletta, accedendo all’area clienti MyFiora o contattando i numeri di Attenzione al cliente.
È comunque facoltà del gestore accogliere eventuali richieste che non ricadono nel suddetto perimetro.
RICORDA
Il mancato rispetto delle scadenze di pagamento comporta la disattivazione automatica del piano rate, rendendo necessario il versamento dell’importo residuo in un’unica soluzione.
È l’insieme delle operazioni necessarie a collegare un immobile alla rete idrica.
Se l’immobile è sprovvisto dell’allaccio fognario è necessario richiedere contestualmente l’allaccio alla pubblica fognatura.
Se non l’hai ancora fatto, registrati all’area clienti MyFiora e accedi alla sezione Preventivi/Nuovo allaccio e completa il form dedicato: sarai contattato da un operatore che gestirà la tua richiesta
RICORDA
Al momento della richiesta avrai bisogno delle seguenti informazioni:
- Dati Anagrafici, C.F. / P.IVA, indirizzo email e copia del documento in corso di validità
- Dati allaccio pubblica fognatura
- Titolo sull’Immobile (proprietario, locatario ecc.)
- Dati catastali
- Dati regolarità urbanistica
Dopo aver verificato che il guasto non riguarda il tuo impianto privato, contattaci per segnalare la problematica attraverso la app MyFiora accedendo alla sezione Segnalazione Guasti: in qualunque momento potrai visualizzare lo stato di avanzamento della tua segnalazione.
In alternativa, solo per segnalazione di guasti, puoi contattare il numero verde 800 356935, attivo tutti i giorni 24 ore su 24.